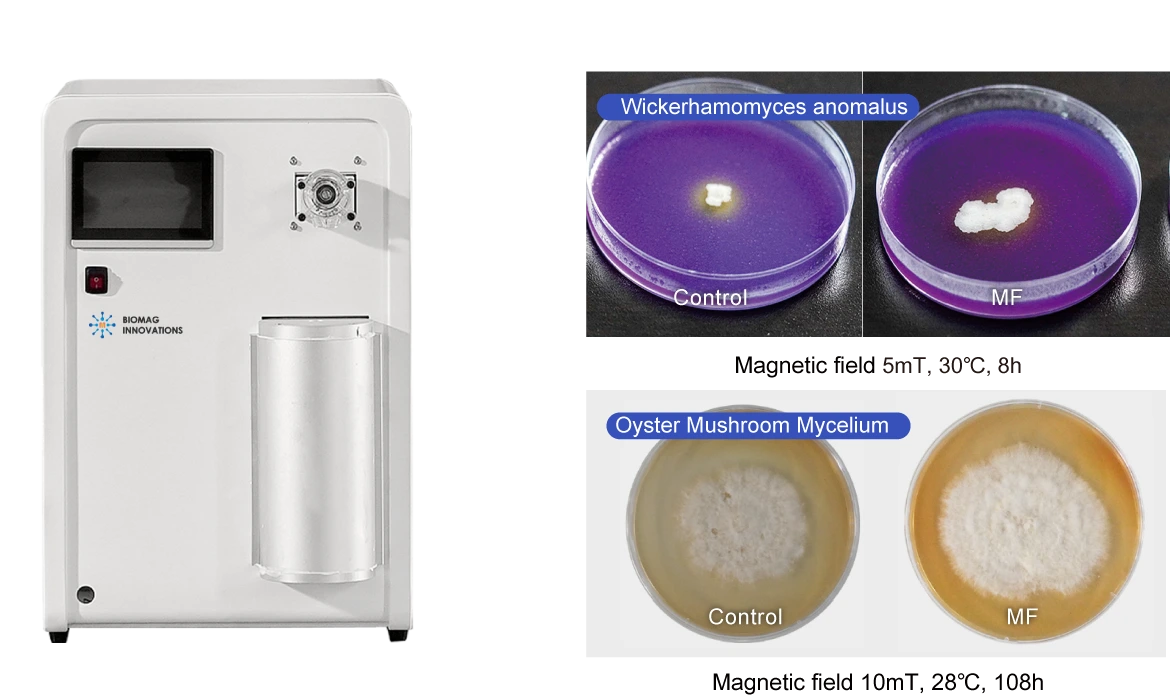

Customer Cases
-
Biomag Revolutionizes Food Preservation with Breakthrough Magnetic Field Technology
Biomag Revolutionizes Food Preservation with Breakthrou […]
-
【Jiangnan University】Enhancing Frozen Meat Quality with Magnetic Field Technology
【Jiangnan University】Enhancing Frozen Meat Quality with […]
-
【Customer Case】Static Magnetic Field Boosts Production Offering Green Solution for Food Industry
【Customer Case】Static Magnetic Field Boosts Production […]